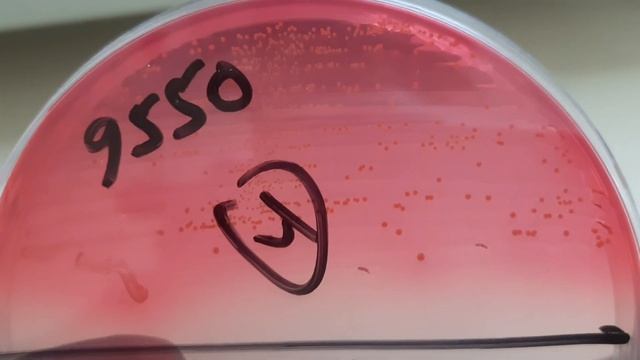
Enterococcus faecium Colony Morphology and Microscopy смотреть онлайн

Автор / Канал: Делай Сам для Души Страница 5

Готовим пиццу без теста.

Как настроить яркость в режиме ультра для комфортной игры
Enterococcus faecium Colony Morphology and Microscopy

Кладоискатели Путешествие в забытые места

"Комплексное психолого-педагогическое сопровождение детей старшего и дошкольного возраста.

САМОСТОЯТЕЛЬНО ПОБРИТЬСЯ на природе

Does barrel length make a speed difference

Схематозы # Где взять трафик на товарку? льем на похудение! 2020

Рисунок по клеточкам. Амонг Ас с красными рогами

Морфологический анализ имени прилагательного. Выборочное изложение

Замена ремешка на Casio PRG-240, GW-3000 - Китай спешит на помощь

Правила мини-баскетбола

"Мамы, отправляя детей в школу, крестите их, пожалуйста, во имя Отца и Сына и Святого Духа."

Как поставить свой рингтон на iphone без itunes

Абрау-Дюрсо магазины и экскурсия на завод

Начало полового созревания возраст (9-12 лет)

Приглашение в группу во вконтакте "Трейдинг по-русски"

Настройка арбалетов Интерлопер. Кучность арбалета и ответы на вопросы.

?ЭКОЛОГИЯ В СОЧИ 2019 ? / ПОЧЕМУ ЛЮДИ ПЕРЕЕЗЖАЮТ В СОЧИ? / ОБЗОР МОЕГО УЧАСТКА

ДИЙКСТРА И ЕГО КАЗНА | Ведьмак 3: Дикая Охота. Прохождение

Microsoft Word 2010 Equation Editor

Как попасть в ТОП выдачи Яндекса по низкочастотным запросам.

Как почистить любую видеокарту Nvidia GEforse 250 gts от пыли !!!!!

ОБУЧЕНИЕ. Урок 2. Как самому озвучить видео- абсолютно просто . Программа Camtasia Studio
За каждым успешным каналом стоит личность, идея и сотни часов кропотливого труда. Если вы здесь, значит, автор «Делай Сам для Души» уже сумел зацепить ваше внимание своим уникальным стилем или подачей. А мы на RUVIDEO позаботились о том, чтобы вы могли изучить весь архив его работ в максимально комфортных условиях — без лишней суеты и преград.
Почему за работами канала «Делай Сам для Души» так интересно наблюдать? Всё просто: это честный контент, который находит отклик в сердцах зрителей. На нашем ресурсе вы можете смотреть онлайн все видео любимого автора бесплатно и в хорошем качестве. Нам важно, чтобы вы видели каждую деталь и слышали каждый нюанс, поэтому мы используем только стабильные плееры из открытых источников Rutube.
Следите за новинками канала, пересматривайте старые шедевры и открывайте для себя новые грани творчества «Делай Сам для Души». Мы постоянно обновляем ленту, чтобы у вас под рукой всегда были самые свежие выпуски. Никаких сложных регистраций — только вы и творчество, которое вдохновляет. Приятного вам путешествия по миру авторского контента на RUVIDEO!
Видео взято из открытых источников Rutube. Если вы правообладатель, обратитесь к первоисточнику.